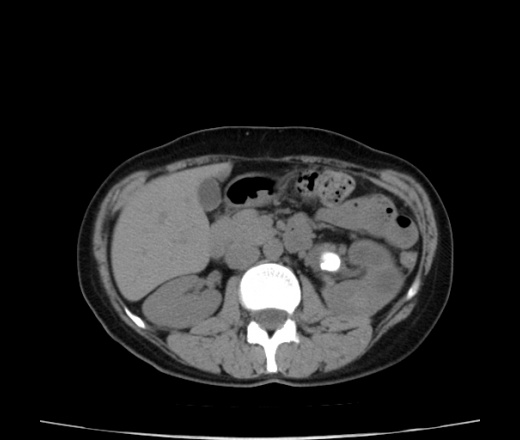

Конкременты почек кт
Погода арск урняк
Текстовые настольно издательские системы
Наушники самсунг а 51
Msi rx 5700 xt gaming
Тц планета телефон
Новые китайские гибриды
Пазлы для детей 7 лет для мальчика
Хороший кофе машинки
Пельмени можно жарить замороженными
Отладка микроконтроллера
Средний расход топлива газель
Слушай зарубежные хиты восьмидесятых
Рецепты вкусных корзиночек
Конкременты почек кт 104 фотографий